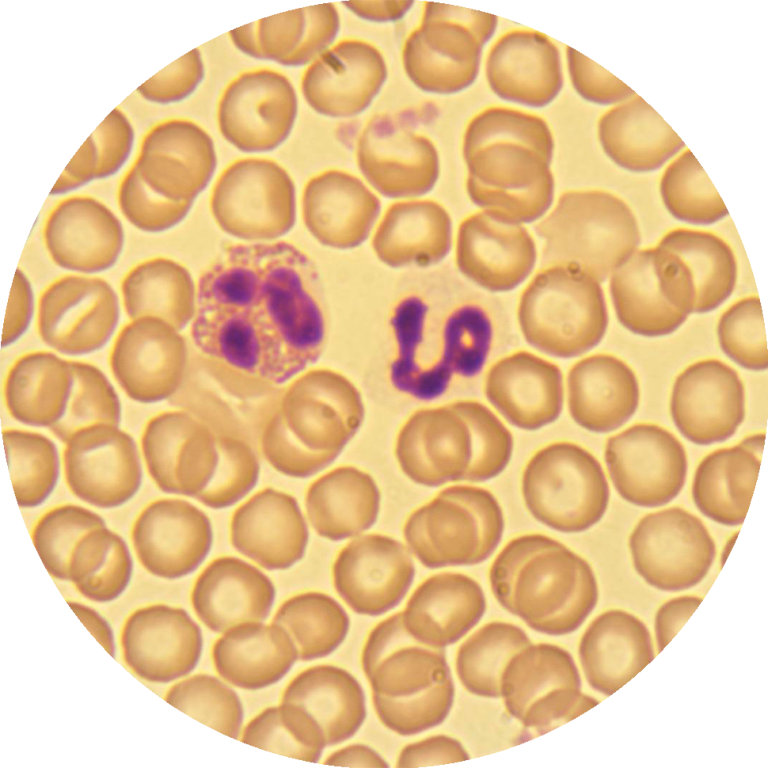
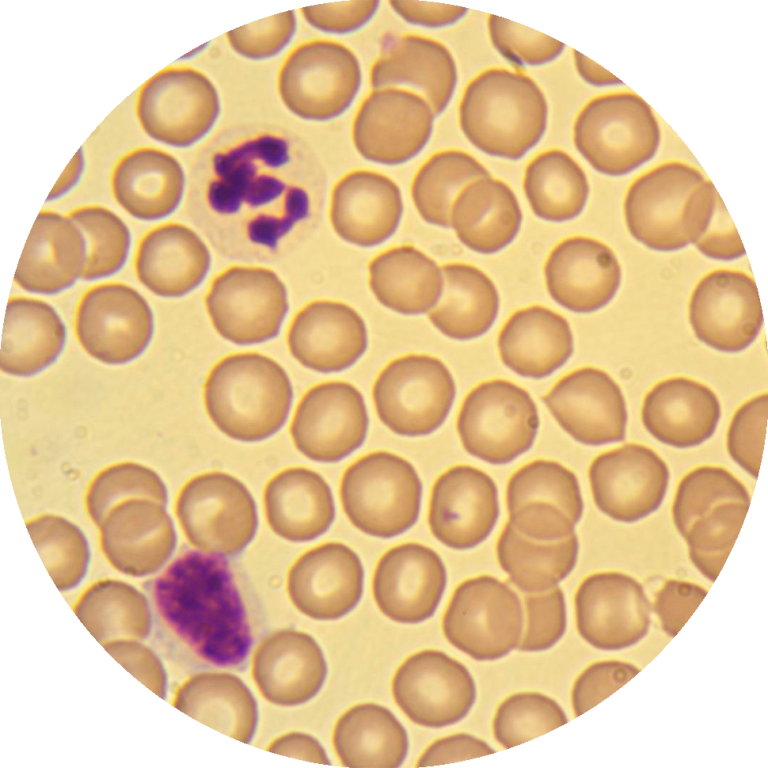
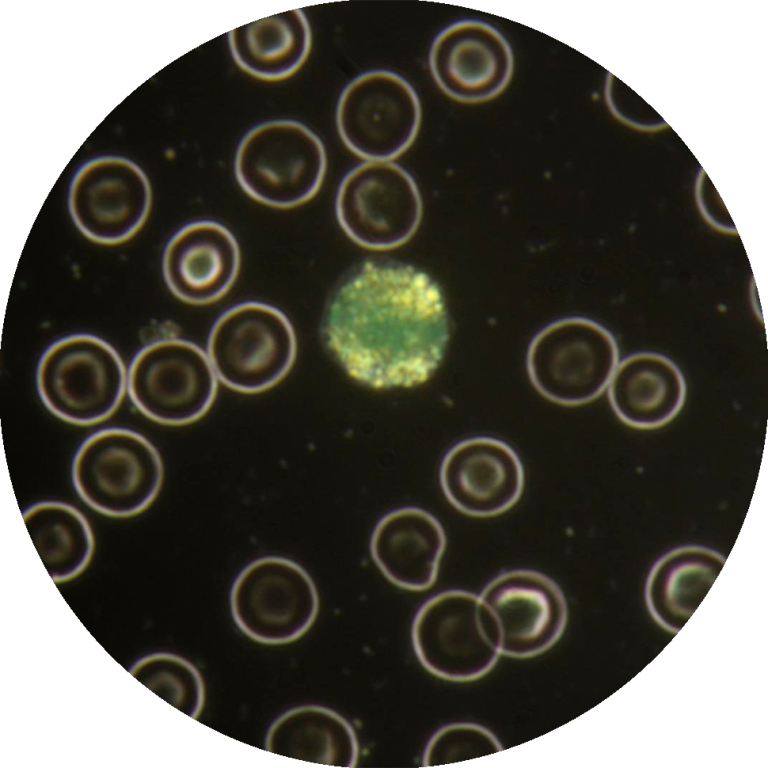
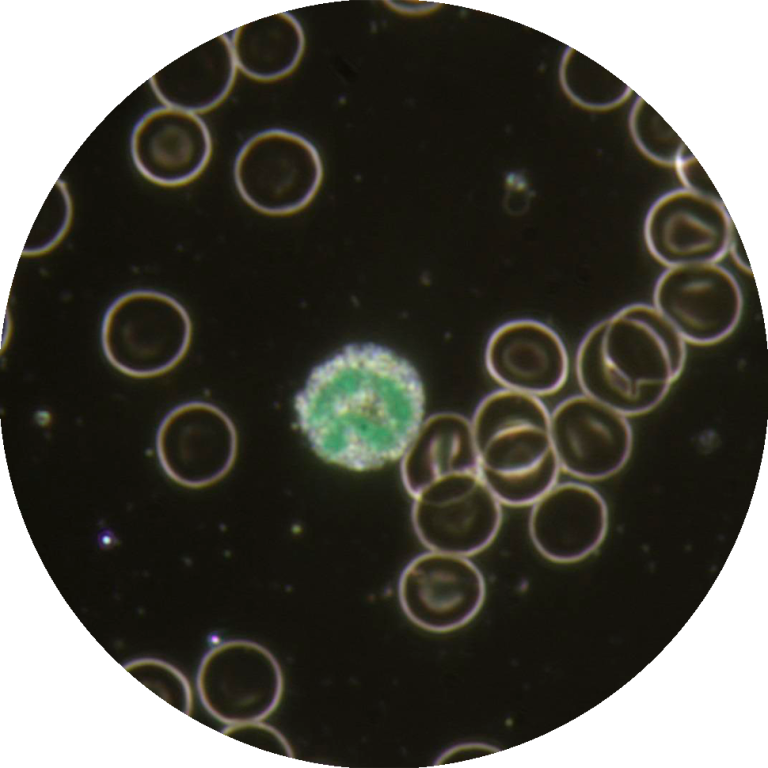
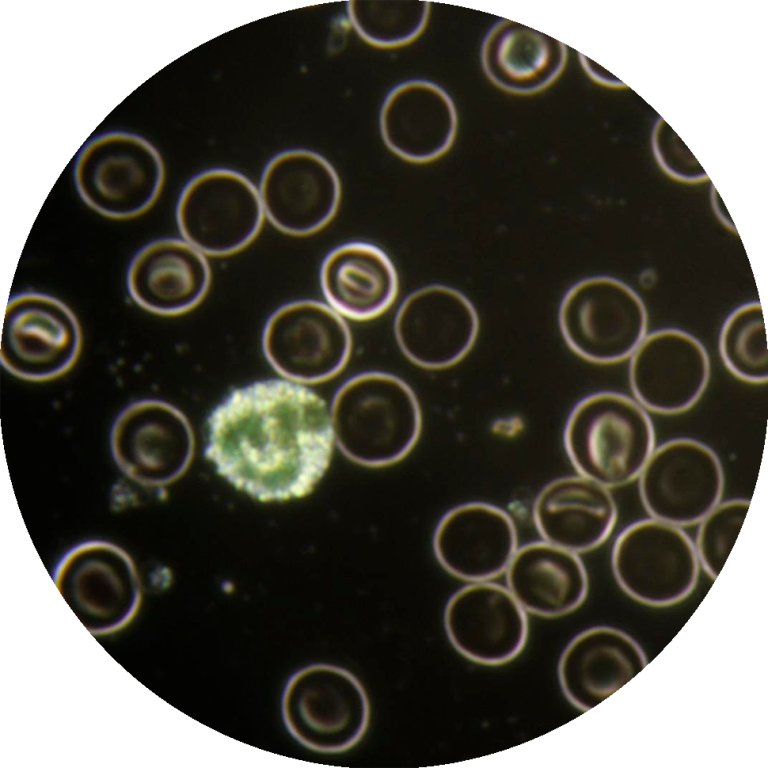

O Curso Avançado de Microscopia para Análise de Parasitas é uma formação essencial para profissionais que desejam aprofundar as suas capacidades no diagnóstico parasitário, utilizando as poderosas técnicas de microscopia de campo claro e campo escuro. Este curso é uma imersão nas nuances da parasitologia diagnóstica, focando na identificação precisa de parasitas em amostras de sangue e fezes dos nossos pacientes.
O diagnóstico parasitológico preciso é um pilar fundamental na medicina preventiva e terapêutica. A capacidade de identificar corretamente parasitas, seja no sangue circulante ou nas fezes, é crucial para a implementação de tratamentos eficazes, o controlo de zoonoses e a gestão da saúde pública. Este curso vai além do básico, explorando métodos avançados de concentração e coloração, bem como a aplicação da microscopia de campo escuro, uma técnica que pode revelar detalhes morfológicos e comportamentais de parasitas no seu estado vivo, complementando a visão tradicional do campo claro.
Este programa foi meticulosamente desenhado para aprimorar as competências em diagnóstico parasitológico microscópico. Ao final do curso, os nossos principais objetivos são:
Dominar Técnicas de Preparação de Amostras: Capacitar os alunos na preparação de amostras de sangue e fezes, incluindo métodos de concentração e coloração avançados, para maximizar a deteção de parasitas.
Aplicar Coloração para Microscopia de Campo Escuro: Realçar detalhes morfológicos e estruturas específicas por forma a distinguir com maior facilidade famílias de células e elementos vivos de artefactos.
Aprofundar a Identificação Microscópica: Fornecer conhecimentos detalhados sobre a morfologia e ciclos de vida dos principais parasitas encontrados em amostras sanguíneas (ex: Babesia, Anaplasma, Dirofilaria) e fecais (ex: ovos e oocistos de nematóides, cestóides, trematóides e protozoários), utilizando as modalidades de campo claro e campo escuro.
Utilizar a Microscopia de Campo Escuro: Ensinar a aplicação da microscopia de campo escuro para a visualização de parasitas no seu estado vivo, permitindo a observação de motilidade e características que podem perder-se em preparações fixas.
Diferenciar Artefactos de Parasitas: Desenvolver a capacidade crítica de distinguir estruturas parasitárias reais de artefactos e contaminantes, evitando diagnósticos erróneos.
Interpretar Achados no Contexto Clínico: Habilitar os participantes a correlacionar os achados microscópicos com os sinais clínicos dos pacientes, otimizando o diagnóstico e a escolha do tratamento.
Convidamo-lo a juntar-se a nós para aprofundar os seus conhecimentos e competências na identificação de parasitas, contribuindo significativamente para a saúde e bem-estar dos seus pacientes.
Em Portugal, as doenças parasitárias e transmitidas por vetores (mosquitos, carraças, piolhos ou pulgas) estão largamente subdiagnosticadas, quer por desconhecimento da sua existência/prevalência ou dificuldade na identificação clínica e sintomatologia.
As doenças parasitárias têm vindo a disseminar-se como resultado de alterações climáticas, demográficas e sociais, bem como alterações genéticas nos agentes infeciosos, resistência dos vetores a inseticidas e mudanças nas práticas de saúde pública.
Algumas doenças transmitidas pelos principais vetores são consideradas de maior mortalidade e morbilidade a nível mundial. A malária, a febre recorrente por carraça, a borreliose de Lyme, a tularémia, a febre Q, a erliquiose, a anaplasmose, a babesiose, a febre escaro nodular e outras riquetsioses são as mais conhecidas. No entanto, são apenas algumas das inúmeras patologias que necessitam de um diagnóstico clínico preciso e diferencial.
A microscopia continua a ser a técnica laboratorial de eleição para o diagnóstico de infeções parasitárias, sendo as técnicas de coloração, usadas na preparação da amostra, o fator decisivo para um diagnóstico correto e eficaz.
O curso avançado de microscopia de campo escuro e claro vai muni-lo do conhecimento e técnica essenciais à prática clínica diária com microscópio ótico.

Edições Anteriores
Cursos Avançado de Microscopia Campo Escuro e Claro
3ª EDIÇÃO
Nível Avançado
Técnicas Especiais de Coloração na Detenção de Microrganismos e Diagnóstico de Patologias
2ª EDIÇÃO
Nível Avançado
Técnicas Especiais de Coloração na Detenção de Microrganismos e Diagnóstico de Patologias
1ª EDIÇÃO
Nível Avançado
Diagnóstico de Infeções Parasitárias









































































































































































































